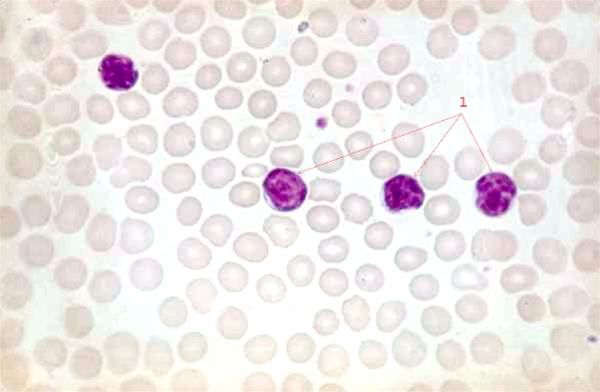
blod-kronisk lymfatisk leukemi x 40

Kronisk lymfatisk leukæmi (x 40)
40 x forstørrelse af bloddråbe i mikroskop. Bloddråben er strøget ud på lille glasplade, hvorefter der er tilsat farver, så cellerne ses tydeligt i mikroskopet.
1) Der ses 4 hvide blodlegemer (lymfocytter (= CLL-celler)) med stor kerne og sparsomt cytoplasma. Disse celler er omgivet af talrige og noget mindre røde blodlegemer (= erytrocytter).
Indhold leveret af
Patienthåndbogen
laegehaandbogen@dadl.dk
Patienthåndbogen
Kristianiagade 12
2100 København Ø
Disclaimer: Patienthåndbogen